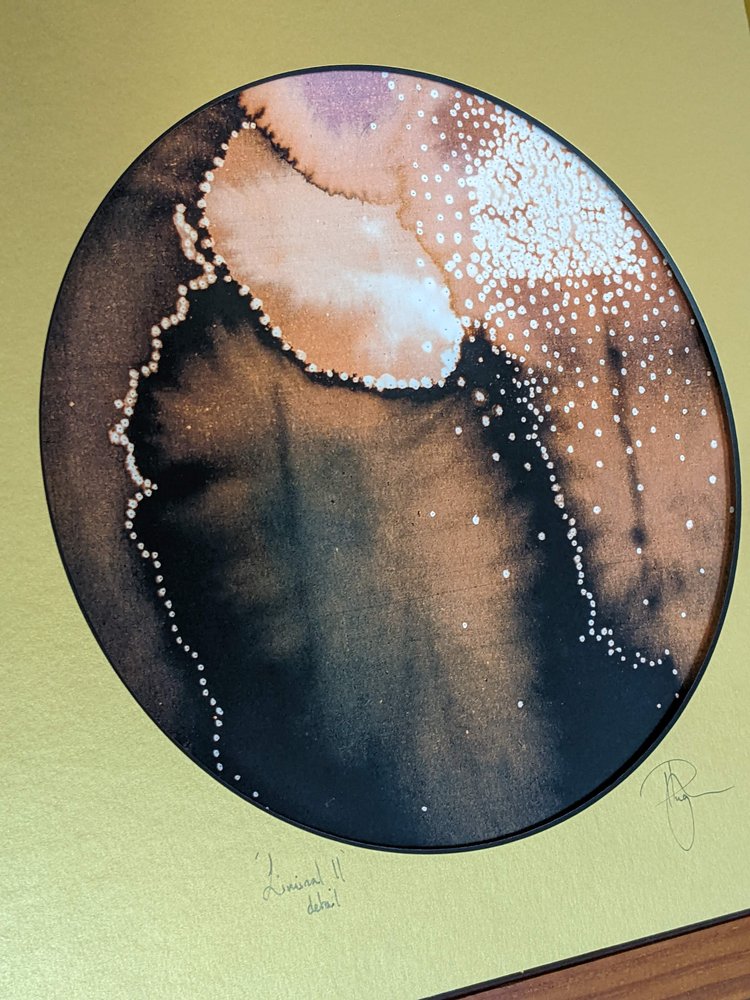

Liminal II detail print. Circular mount
Liminal II detail print. Circular mount
Couldn't load pickup availability
Balancing between above and below, rich hues suggest infinite depths and soaring cosmos. Scattered with pinpricks of light that ebb and flow with the contours.
Created from a section of the inimitable Liminal II painting that launched All Is Not Lost art.
32cm sq
Available in two colourways, Ochre and Teal. Liminal II is also available as the whole painting
Fine art giclee print, signed, embossed and hand finished with gold leaf by me in the studio.
Printed on 280gsm Fine Art Paper using vivid archival quality inks by Iris Print, a small family run business based near Malvern in the UK.
Hand finished embellishment will vary with each print ensuring your artwork is unique.
For Commissions:
Book a consultation
Delivery
Delivery
Prints on paper.
All prints will be posted carefully packaged and rolled in a tube, unless you specify that you want them posted out flat by contacting me, or they already have a cardboard mount.
They will need flattening before you frame them. I suggest using something soft such as bean bags to hold down the corners and edges for at least 12 hours. Be careful to avoid marking the paper and make sure you’ve got clean hands before handling - or just let a framer deal with it all!
Postage costs for rolled unmounted prints posted to an address within the UK are included in the sale price.
Collection from the All Is Not Lost Art Studio is available by appointment, this may or may not include a cup of tea and a biscuit.
Prints on stretched canvas.
I will find the most cost effective quote for your canvas to be delivered and pack it for the highest quality protection.
I will correspond via email (or your preferred method) to provide you with a quote for postage, packing and delivery, as well as tracking.
Collection from the All Is Not Lost Art Studio is available by appointment, this may or may not include a cup of tea and a biscuit.
Framing & Install
Framing & Install
All paintings have hanging fixtures attached to the back and will be supplied ready to hang unless otherwise specified.
As with all original works of art I do not recommend hanging in direct sunlight. Due to the nature of the media used the hues of your painting may evolve very slowly over time. This is part of the beauty of All Is Not Lost’s inimitable alchemical style.
I have a very experienced and capable, professional Gallery technician at my disposal. If you would like us to deliver and install/hang your painting please get in touch.